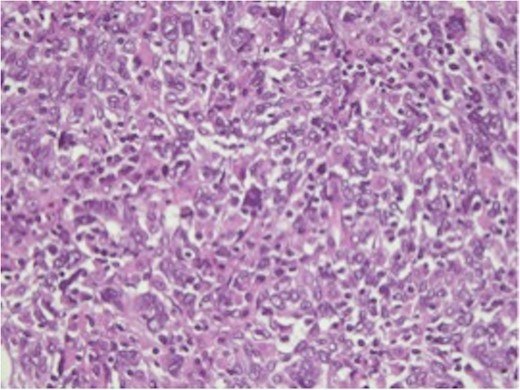

-
PDF
- Split View
-
Views
-
Cite
Cite
Alessandra Cristaudi, Jessica Barizzi, Raffaele Rosso, Marco Varini, Mario Alerci, Laura Rubbia Brandt, Pietro Majno, Ruben Carlo Balzarotti Canger, Medullary-like hepatocellular carcinoma, Journal of Surgical Case Reports, Volume 2018, Issue 2, February 2018, rjy010, https://doi.org/10.1093/jscr/rjy010
- Share Icon Share
Abstract
Hepatocellular carcinoma (HCC) is the most frequent primary hepatic cancer. Pathological features can define the biological behavior and prognosis. Medullary-like HCC is a very rare variant that has been described only twice in literature. In the present study, we report the case of a non-cirrhotic 72-year-old man, who presented two HCC lesions on routine screening for hepatitis C virus liver disease. Radiological imaging and biopsy showed two different subtypes: one classic HCC, which was treated with chemoembolization, and a second PET/CT-positive carcinoma with a PET/CT-positive metastatic coeliac lymph node, which was resected laparoscopically with a left lateral sectionectomy and extended lymphadenectomy. Histopathology revealed a medullary-like HCC; lymph node analysis confirmed the metastatic nature of the PET/CT-positive coeliac node and showed an incidental B-cell lymphoma in the hepatic pedicle lymph nodes. To the best of our knowledge this is the third case of medullary-like HCC described in the literature, and the first associated to a concomitant typical HCC.
INTRODUCTION
Hepatocellular carcinoma (HCC) is the most frequent primary hepatic lesion in adults, with more than 600 000 new cases/year worldwide. It most often develops on the background of chronic liver disease, generally at the stage of cirrhosis [1, 2]. Its diagnosis is mainly based on radiological imaging and α-fetoprotein. Treatment varies from liver transplantation, surgical resection, transarterial chemoembolization (TACE), selective internal radiation therapy, local ablation with radiofrequency or microwaves, stereotactic radiation to systemic chemotherapy [3]; there is a recent effort in favor of adapting the management to individual tumor characteristics, including histology and molecular analysis [4].
Classical prognostic factors of HCC are the size and number of the lesions, and histological features such as differentiation, capsular invasion, micro- and macro-vascular invasion or proliferative activity [5]. In addition, some particular forms of HCC can be associated with a better prognosis, as the fibrolamellar type, or the lymphocytic-type HCC [6]. A rare form of HCC is the medullary-like type, that—to the best of our knowledge—has been described only twice by Zimmermann et al. [7] and by Quist et al. [8]
We describe here the third case of medullary-like carcinoma, in a patient presenting at the same time an additional classical HCC and a B-cell lymphoma.
CASE REPORT
A 72-year-old man was known for a chronic HCV infection, treated with success in the past with actual undetectable viremy. On routine ultrasound screening, a hepatic nodular lesion was found in segment 8 (S8). Alpha-fetoprotein was low (4.7 ng/ml) and liver function was normal. A 4-phase CT-scan confirmed a 5.5 × 4.7 × 5.2 cm3 lesion typical for HCC, and showed a second 2 cm hypovascular lesion in segment 2 (S2) (Fig. 1). The staging was negative for distant metastases, but a 4.6 × 3.7 × 4 cm3 lymph node was observed in the coeliac region, retrospectively present on a CT-scan made 3 years before. The MRI confirmed the CT findings. A percutaneous US-guided biopsy of the S8 lesion confirmed a classical HCC, with a trabecular growth pattern, while a biopsy of the coeliac node, by US-endoscopy, showed carcinoma cells. After initial proposition of a palliative treatment with Sorafenib, the patient’s case was re-assessed, basing on the possibility of two different lesions: a classical hypervascular HCC in S8, and a hypovascular and slow growing second one in S2 with a positive lymph node. An F18-FDG PET scan showed a clear hypermetabolism in the S2 nodule and in the coeliac lymph node, while no capitation was found in S8 lesion.

(A) Venus phase of dynamic CT-scan showing two hepatic nodules (classical HCC in S8 and medullary-like HCC in S2) and (B) large lymph node in the coeliac region.
A multimodal minimally invasive approach was decided at multidisciplinary board.
The S8 HCC lesion was successfully treated with TACE (lipiodol-epirubicin injection), while the second lesion was resected laparoscopically with a lateral left sectionectomy and a complete lymphadenectomy of the hepatic pedicle and coeliac trunk, including a large lymph node of the common hepatic artery (Figs 2 and 3).

Segment 8 nodule treated with transarterial chemoembolization.

Treatment of Segment 2 nodule: (A) laparoscopic lateral left sectionectomy; (B) left hepatic vein stapling; (C) complete lymphadenectomy with excision of the lymph nodes in the coeliac region; and (D) specimen extraction through a minilaparotomy.
The postoperative course was uneventful and the patient was discharged home 5 days after the operation.
Surprisingly the final pathologic analysis revealed a medullary-like hepatocarcinoma, pT1, pN1 (coeliac node), R0. To date, after 12 months follow-up, the patient is alive and disease-free.
Pathological results and description
Macroscopic examination revealed a white subcapsular tumor of 1.8 × 1.6 × 1.5 cm3, at 0.6 cm distance from resection margin (Fig. 4). No cirrhotic changes were found. All others resected specimens were 12 lymph nodes, and a large node of 4 × 3 × 3 cm3.

Microscopically, the hepatic lesion showed hepatocellular elements with solid and partly syncytial growth pattern. The nuclear atypies and mitotic figures were important (Fig. 5). A dense lymphoplasmatic infiltration prevalent in the periphery was found (Fig. 6). The immunohistochemical analysis showed membranous staining for β-catenin (Fig. 7). No immunoreactivity of tumor cells was detected for HerPar (Fig. 8), CK 7b (Fig. 9), AFP, S-100, EBV and EBER. Mismatch repair proteins (MMR) retained immunohistochemical staining. Immunohistochemistry for light Ig clearly showed that the plasma cells in the infiltrates were polyclonal. This configuration is typical of a medullary-like HCC.
H&E-stained slide, ×50. Large anaplastic cells with enlarged vesicular nuclei, prominent nucleoli and numerous mitoses.

H&E-stained slide, ×50. Periphery of the tumor with dense lymphoplasmacytic infiltrate.

Immunohistochemistry for β-catenin, ×50. The tumor cells showed membranous staining for β-catenin.

Immunohistochemistry for HEP, ×50. The tumor cells showed negativity for HepPar.

Immunohistochemistry for CK 7, ×50. The tumor cells showed negativity for cytocheratin 7.
Lymph nodes were all negative except the largest one mentioned previously, which was positive for poorly differentiated tumoral tissue.
After the immunohystological assessment of the lymph nodes, a B-cell lymphoma of the marginal zone was found.
DISCUSSION
HCC is the most frequent primary hepatic tumor [9]. Understanding the pathological features of this tumor can help predicting its biological behavior and prognosis and to adapt treatment accordingly. The case reported is, to the best of our knowledge, the third medullary-like HCC described in literature, the second found in Switzerland and the first associated to a typical HCC. The previous cases reported by Zimmermann et al. [7] and by Quist et al. [8] were cirrhotic and non-cirrhotic patients respectively but present some pathological similarities to our case. All three cases presented a syncytial growth pattern with a dense lymphoplasmatic cell infiltration, in particular in peripheral zones. MMR and β-catenin immunohistochemical retention was found similarly to the previous cases. Other immunohistochemical features (HerPar, CK 7, AFP, S-100 and EBER), were not found contrarily to the previous ones. EBV search was negative in all three cases. At present, it is not clear which histological features could be associated to a better prognosis.
Concerning the treatment choice for this patient, it was based on the patient’s good general conditions, the presence of two different tumors, the slow growth of the coeliac lymph node, and the possibility of a minimally invasive surgical option. A non-evidence-based treatment was consensually decided at a second multidisciplinary discussion. The prognostic value of this pathologic diagnosis is still unclear, as only one of the previous cases had a better outcome and the long-term follow-up was not available. In our case, the patient is disease-free at 12 months from treatment.
Medullary-like HCC remains a rare lesion, probably. Its prognostic value is unclear. More knowledge must be gained in molecular and immunohystological features to improve the understanding of its biological specificity and, possibly, to optimize the treatment.
CONFLICT OF INTEREST STATEMENT
None declared.
FUNDING
Ospedale Regionale di Lugano, Servizio di Chirurgia.